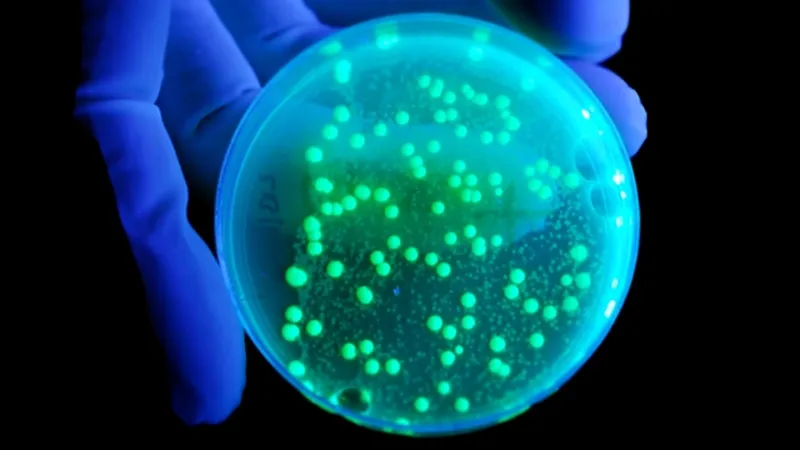
"الصحة العالمية": انتشار المرض "X" مسألة وقت.. ويجب الاستعداد له من الآن

"الصحة العالمية": انتشار المرض "X" مسألة وقت.. ويجب الاستعداد له من الآن
أبرزت منظمة الصحة العالمية الخطر المحتمل لمسبب مرض افتراضي أُطلق عليه اسم "المرض X" والذي قد يسبب جائحة تسبب وفيات أكثر من كوفيد 19، وهذا جاء خلال منتدى الاقتصاد العالمي، ويؤكد الحاجة الملحة للاستعداد للأمراض المجهولة.
ما هو المرض X؟
المرض غير معروف حتى الآن، ولكن قد يؤدي إلى أزمة صحية عالمية، وقُدم هذا المفهوم في 2018 كجزء من خطة لمنع الأوبئة، وهي خطة تركز على الأمراض التي قد تشكل تهديدًا كبيرًا، وهذه المبادرة تهدف إلى ضمان بقاء المجتمع الدولي يقظًا ومستعدًا للأمراض الغامضة، واختبرت الجائحة السابقة التي تسببت في وفاة 7 ملايين شخص الاستجابة العالمية للأوبئة، وأظهرت أهمية تطوير اللقاحات، ويؤكد تركيز المنظمة على المرض X الدروس المستفادة من جائحة كوفيد 19.
اقرأ أيضًا: منظمة الصحة العالمية تصدر توصيات جديدة لتلقي لقاحات كورونا
وأكد المدير العام للمنظمة على أهمية التوقع والاستعداد، وعلى الرغم من أن هذه المخاوف قد تسبب الذعر، إلا أن المنظمة تتخذ خطوات استباقية مثل إنشاء صندوق للجائحات، وإقامة مركز لنقل التكنولوجيا في جنوب إفريقيا لمعالجة عدم المساواة في توزيع اللقاحات، وهذا التحذير الحالي هو مجرد دعوة للاستعداد للأمراض الخطيرة التي لم نتعرف عليها بعد، لتجنب الكوارث الصحية التي قد تحدث.
شاهد أيضًا:


















